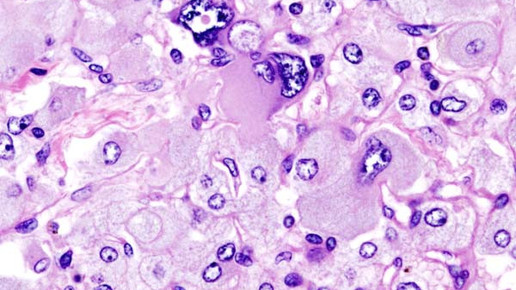
adrenal pheochromocytoma wikipedia cc by sa 3 0

Tumor täuscht ADHS vor
Bestimmte Tumoren können bei Kindern die gleichen Symptome hervorrufen wie das Aufmerksamkeitsdefitsyndrom ADHS. Zu diesem Ergebnis kommt eine Studie des amerikanischen National Institute of Health (NIH). Kinder könnten daher falsch behandelt werden und das Krankheitsbild verschlimmern, warnen die Forscher.
Die Tumorarten Phäochromozytom und Paragangliom sind dafür bekannt, dass sie in hohem Maß Catecholamine sezernieren – Substanzen, die das zentrale Nervensystem stimulieren. Die neuroendokrinen Tumore treten vor allem bei Erwachsenen zwischen dem 40. und 50. Lebensjahr auf – doch immerhin 10 Prozent der Betroffenen sind Kinder, die meist eine genetische Disposition besitzen.
Patienten, bei denen die Tumoren auftreten, klagen häufig über Bluthochdruck. In der Folge treten Herzrasen, Kopfschmerzen oder Schwindel auf. Die Erkrankung geht einher mit einer bösartigen Vergrößerung der Nebenniere, welche unbehandelt tödlich verlaufen kann.
Den Wissenschaftlern des NIH fiel auf, dass einige Symptome denen ähneln, die bei Kindern mit ADHS auftreten. Sie evaluierten daher die Daten von 43 Kindern, die unter einer oder beiden Tumorarten litten, um einen möglichen Zusammenhang zwischen der Krebserkrankung und ADHS zu untersuchen. Die Daten wurden zwischen 2006 und 2014 erhoben.
Neun Kinder waren vor der Entdeckung der Tumoren bereits mit ADHS diagnostiziert worden. Vier davon erhielten Medikamente wie Amphetamin, Dextroamphetamin oder Methylphenidat. Diese wurden nach erster Einschätzung der behandelnden Ärzte aber nicht gut vertragen: Die Kinder klagten regelmäßig über Kopfschmerzen und starkes Schwitzen. Bei den Patienten wurde zusätzlich Bluthochdruck festgestellt, eine im Grunde bekannte Nebenwirkung, die bei Kindern aber in der Regel nur geringfügig ausgeprägt ist.
Nach der operativen Entfernung der Tumoren zeigten drei der neun Kinder plötzlich keine ADHS-Symptome mehr. Die Studienleiter vermuten daher, dass die Krebserkrankung – und nicht eine Aufmerksamkeitsstörung – für die Symptome verantwortlich ist. Für die Forscher ist klar: Insbesondere bei gleichzeitigem Auftreten von Bluthochdruck und der Diagnose ADHS könnte auch ein Tumor die Ursache sein. Die solle in Zukunft stärker in den Fokus gerückt werden, um eine potenzielle Krebserkrankung nicht unnötig lange unbehandelt zu lassen, so die Wissenschaftler.
Die Prävalenz von diagnostizierter AHDS sei bei den Kindern im Rahmen der Studie mit 21 Prozent außerdem deutlich höher als in der Bevölkerung bei gleichaltrigen Kindern, so die Forscher. Normalerweise trete die Aufmerksamkeitsstörung nur bei etwa 7 Prozent der Kinder auf – ein weiterer Hinweis, dass die Tumoren die ADHS-Symptomatik imitieren und möglicherweise die eigentlich zugrunde liegende Krankheit ist.

APOTHEKE ADHOC Debatte